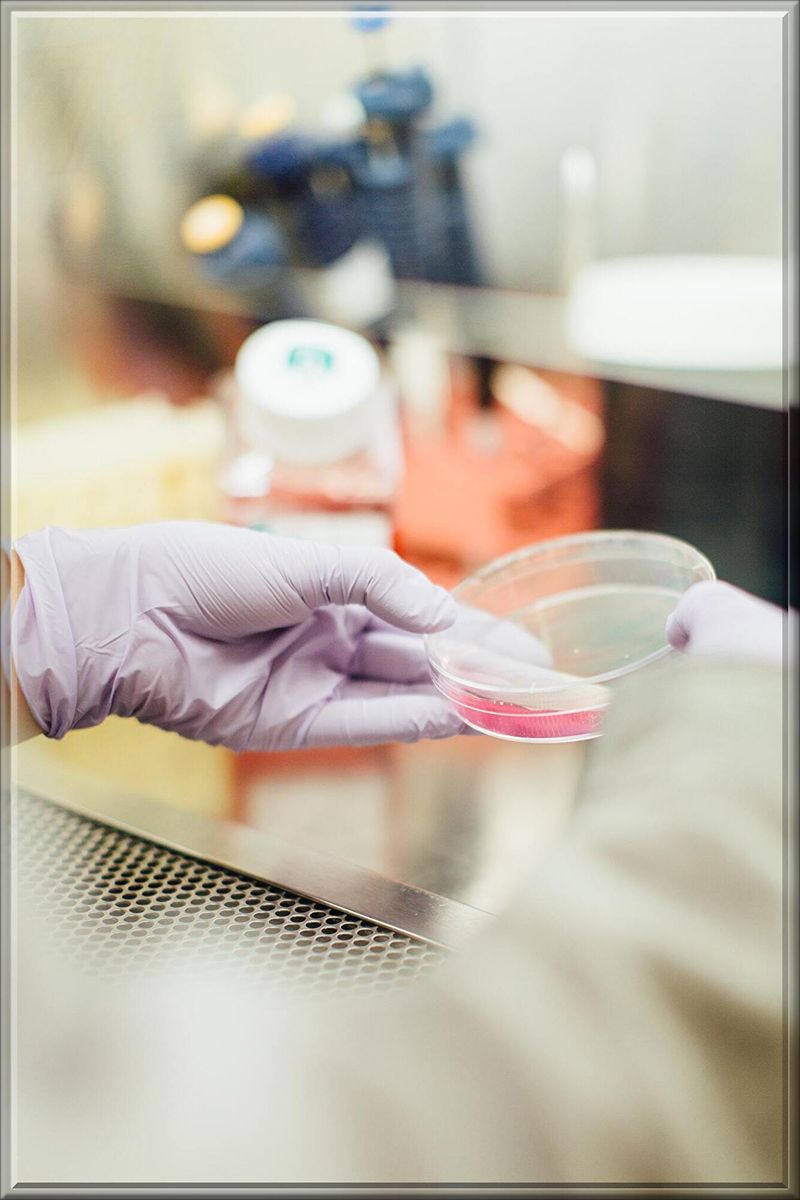
Content image

とうとう以前より簡単に
30歳若返る方法が発見され
世界中が歓喜し
全米が泣いてます!
それは
人間のどの部位も人工的に作れる
「iPS」細胞という物を使い
若返る方法です。
この「iPS」細胞とは
iPS細胞に人の遺伝子を入れると
どんな部位にも変化できる
スーパー細胞です。
この細胞に制作したい
人の部位の遺伝子情報を入れると
どんどんその部位に変化して
人工的にどの部位でも作れます。
心臓や胃や肝臓や肺や皮膚や骨や
脳まで人工的に作れて
IPS細胞に入れた遺伝子を持つ人に
移植する事が出来ます。
この「iPS」細胞を発見した人は
日本人の「山中伸弥博士」で
2007年にノーベル賞を
受賞してます。
しかし人工的に作った人の部位を
そのまま移植しても
神経が無くただの物体なので
移植時にいくつか工程が必要です。
〓=〓=〓=〓=〓=〓=〓=〓=〓=〓=〓
移植方法は
まず最初に人の細胞から
遺伝子を取り出します。
そして
レトロウィルスに入れて
ウィルスの分裂力を使い
遺伝子も一緒に分裂させます。
すると遺伝子が
このウィルスの中で細胞化し
「iPS」細胞という物に
変身してくれるのです。
この細胞の中にある遺伝子に
作りたい部位の情報を入れると
「iPS」細胞が分裂して
作りたい部位が出来上がります。
しかしこのままでは
移植しても神経が無いので
iPS細胞にする時
1つの工程を追加します。
それは
遺伝子入りのウィルスを増やす時
作りたい部分の細胞も
一緒に入れて増やします。
こうする事により
神経も一緒に出来て
他の神経と繋がるので
移植する事が出来ます。

〓=〓=〓=〓=〓=〓=〓=〓=〓=〓=〓
人工的に作った臓器を
ずっと入れ替え続ければ
不老不死が得られると言うのは
まだ技術的に無理です。
それは
脳の移植が出来ない事が
大きな原因になってます。
でも「iPS」細胞を脳に入れ
その場で古い細胞と入れ替えれば
大丈夫じゃないかと思いきや
それもダメなのです。
たとえ死んだの脳細胞と
新品の脳細胞を入れ替えても
なぜか解らないけど
脳が勝手に死んでしまうのです。
この問題が解決する事が出来れば
本当に不老不死になる事が出来
永遠の命が手に入りそうです。
しかし今回の研究は
この事でなく
「iPS」細胞移植までの時間を
短縮できると言う事です。
この時間短縮方法を見つけたのは
イギリス「バブラハム研究所」の
研究者達です。

〓=〓=〓=〓=〓=〓=〓=〓=〓=〓=〓
現在の「iPS」細胞での治療は
悪くなった部分だけを切り取り
そこにiPS細胞を移植し
部分治療を行う方法です。
それは
まだiPS細胞で治療した後の
情報が少く何が起こるか解らず
恐る恐るやってるからです。
今回発見された
時間を短縮できる方法は
レトロウィルスに遺伝子を入れ
培養する時間を短縮できました。
その方は
普通50日間かけて
細胞を増やすのですが
それをたったの13日間にします。
すると
細胞が増える前に
遺伝子が先に増えて行くのですが
その時点で移植しちゃいます。
実験時のiPS細胞は
被験者の皮膚の部分の細胞を取り
その皮膚の遺伝子を使用しました。
そして被験者の
53歳の女性に移植すると
その部分の細胞だけ
23歳の皮膚に変化しました!

〓=〓=〓=〓=〓=〓=〓=〓=〓=〓=〓
移植した皮膚のiPS細胞を調べると
遺伝子を傷つけて老化させる
「メチル基」という物が
遺伝子から洗い流されてました。
そしてテロメアと言う
遺伝子を繋ぐ鎖も
長くなって回復してたのです。
テロメアと言うのは
時間とともに短くって
無くなってしまと寿命が来て
死んでしまう物です。
更に肌にハリとツヤを与える
コラーゲンの生産量も増加し
傷の治りも早くなってたのです。
iPS細胞を保存して置く時
細胞が増える前の
遺伝子だけ増えた状態で止めて
保存しておきます。
この方法を「スンドメ」と言い
今回この状態で保存せず
試しに移植してみようと思い
実際にやってみた実験です。
iPS細胞がもっと研究されれば
不治の病のアルツハイマー等の
治療が出来る様になり
若返り薬も完成させられるかも。












